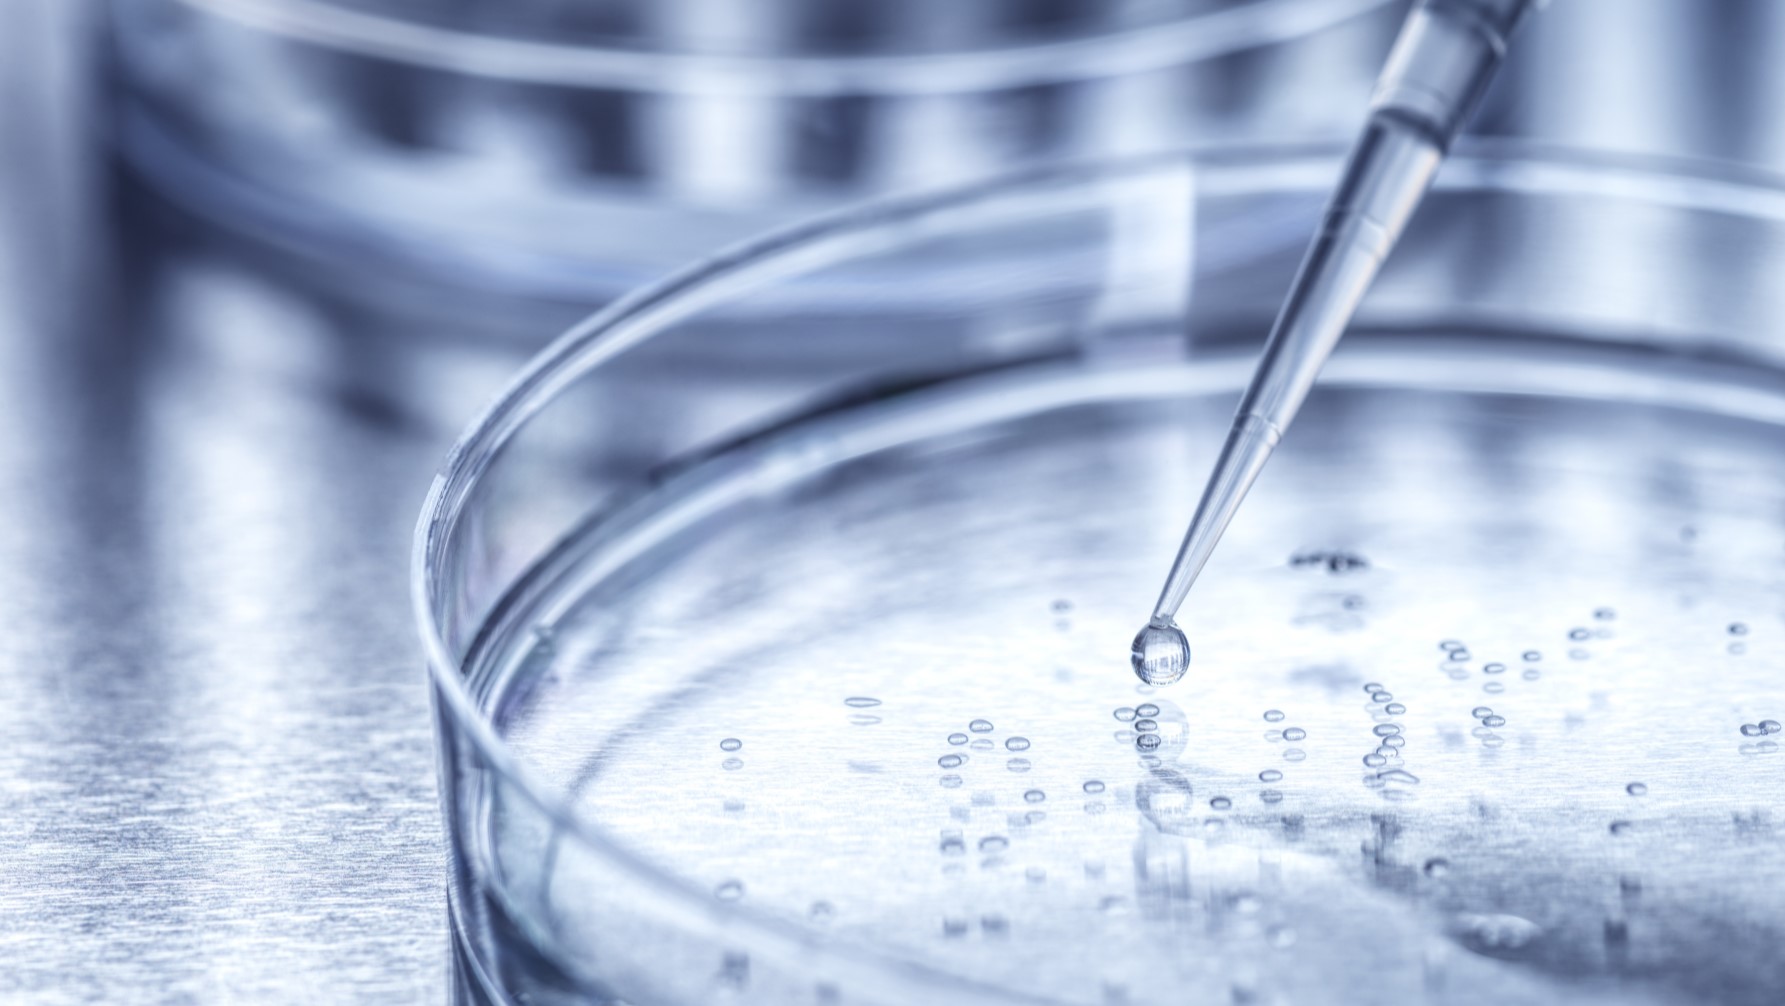

Actualidade
Más allá de proporcionar información relevante sobre las áreas terapéuticas e innovación de Bristol Myers Squibb, nuestras historias revelan el compromiso y la dedicación de las personas que trabajan en BMS realizan cada día en beneficio de los pacientes.